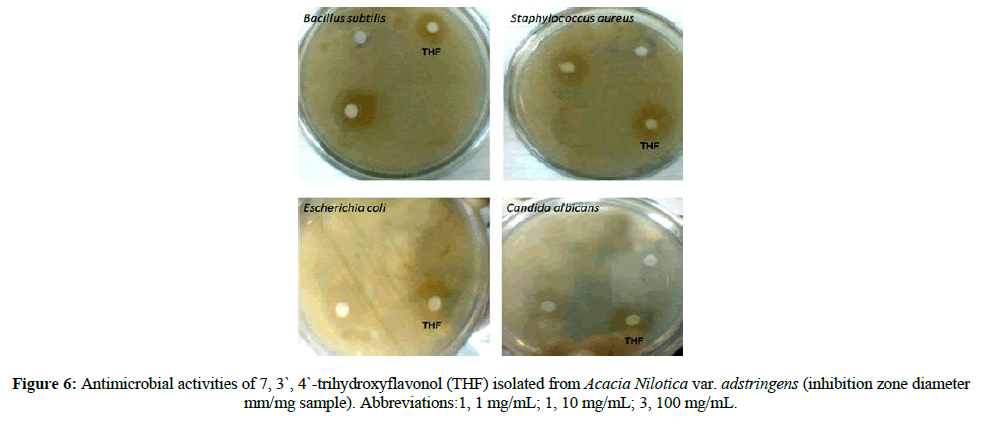

Research Article - Der Pharma Chemica ( 2020) Volume 12, Issue 6
Antimicrobial Activity of 7, 3`, 4`-Trihydroxy flavonol Isolated from Acacia Nilotica Var. Adstringens
Al Hafez M. Alraih1, Mohamed A. Mohamed2, Mohamed A. Alansari3, Abu Baker M. Osman1*, Khalda M. Ahmed1, Ayda Y. Abdelrahman4 and Mohamed E. Hamid52Department of Chemistry, College of Science, Sudan University for Science and Technology, Khartoum, Sudan
3Department of Photochemistry and Plant Systematic, National Research Centre, Cairo, Egypt
4Department of Chemistry, College of Science, Najran University, Najran, KSA
5Department of Microbiology, College of Medicine, King Khalid university, Abha, KSA
Abu Baker M. Osman, Department of Chemistry, College of Science, King Khalid university, Abha, KSA, Email: abubker123@gamil.com
Abstract
Acacia species (Mimosaceae) is widely distributed in tropical and subtropical countries and has a variety of ethnomedicinal uses. There is inadequate laboratory investigation to identify bioactive compounds and therapeutic effect of Acacia nilotica var. adstringens. This research was conducted to extract, isolate and identify major compounds from heartwood of Acacia nilotica var. adstringens and to test them against representative bacteria. Powdered air-dried heartwood of A. nilotica var. adstringens was extracted with methanol/water, 4:1 and the extracted was then purified using chromatographic techniques (column and paper chromatography). A pure flavonoid compound was isolated and the structure was elucidated based on extensive spectroscopic analysis procedures (IR, UV, 1H-NMR, and MS spectrometery). The isolated compound was then evaluated for antimicrobial potential against Gram-negative (Escherichia coli and Pseudomonas aeruginosa) and Gram-positive bacteria (Bacillus subtilis, Bacillus cereus, and Staphylococcus aureus) using cub-plate agar diffusion method. The spectroscopic analysis of the isolated compound led to its identification as 7, 3`, 4`-trihydroxyflavonol. The compound showed varying antimicrobial responses with high potency against Gram-negative human pathogens. The Gram-positive bacteria which were inhibited were Bacillus cereus, Corynebacterium sp., Enterococcus faecalis, Staphylococcus aureus, and Streptococcus agalactiae. The Gram-negative bacteria were Acinetobacter baumannii, Acinetobacter sp., Escherichia coli, Pseudomonas aeruginosa and yeasts were Candida albicans and Cryptococcus neoformans. The present study demonstrated that 7, 3`, 4`-trihydroxyflavonol is an effective antimicrobial compound. If applied in suitable pharmaceutical formulations it could be valuable for treating various bacterial infections or introduced as adjunct treatment along with standard agents.
Keywords
Ethnomedicine, Acacia species, Flavonols, Spectroscopic analysis, In vitro antimicrobial Activity
Introduction
Acacia nilotica is the most significant genus of family Leguminosae firstly described by Linnaeus in 1773 [1]. This plant is therapeutically used as anti-cancer, antiscorbutic, astringent, anti-oxidant, natriuretic, antispasmodic, diuretic, intestinal pains, and diarrhea, nerve stimulant, colds, congestion, coughs, dysentery, and fever [2]. Pods not necklace-like, margins straight or create and rarely narrowly constricted between the seeds, if constricted then only occasionally along with the pod. Branches and pods densely pubescent to tomentose especially when young. Pods often rather wide (1.3 cm-2.2cm) with distinctly and often irregularly crenate margins, it occurrence in Algeria, Burkina Faso, Cameroon, Cape Verde, Chad, French Guiana, Gambia, Ghana, Guinea Bissau, India, Iran, Ivory Coast, Libya, Mali, Niger, Nigeria, Oman, Pakistan, Senegal, Somalia, Sudan, and Togo [3,4]. It uses as an effective medicine in the treatment of malaria, sore throat (aerial part) and toothache (bark) [5].
The powdered bark of the plant with a little salt is used for treating acute diarrhea. 6 The gum or bark is used for cancer of ear, eye, or testicles, induration of the liver, spleen and excess flesh. Bark, leaves, and young pods are strongly astringent due to tannins and are chewed in Senegal as antiscorbutic, park decoction drunk for intestinal pains and diarrhea. Other preparations are used for coughs, toothache, ophthalmia, and syphilitic ulcers. In Lebanon, the resin is mixed with orange-flower and used as an infusion for typhoid convalescence [6,7] Egyptian Nubians believe that diabetics may eat unlimited carbohydrates as long as they also consume powdered pods. 7 Extracts of the plant were found to be inhibitory to at least four species of pathogenic [8].
Flavonoids are natural phenolic compounds which appear as secondary metabolites of the plant, [9] they are found in many plant tissues, which present inside of the cells or on the surfaces of different plant organs. The flavonoids may be modified by hydroxylation, methylation, or O-glycosylation of hydroxyl groups as well as C-glycosylation directly to the carbon atom of the flavonoid skeleton. Also, alkyl groups (or phenyls) may be covalently attached to the flavonoid moieties, and sometimes additional rings are condensed to the basic skeleton of the flavonoid core [10]. Flavonoids occur both in the (Free State) and as glycosides; their chemical structure is based on a C15 skeleton consisting of two benzene rings connected by a three-carbon chain, that is, C6-C3-C6. The three-carbon on chain is generally closed to form a heterocyclic ring (the C-ring) [11]. The position of the substitution also affects the properties. The flavonols containing two ortho or para hydroxyl in the 2-phenyl ring have anti-oxidant properties, while free hydroxyl groups at the 5, 7-positions have a pro-oxidant effect. Apigenin and genkwanin, which are present in the Chinese, drug “Yuen -Hua” are believed to have diuretic and anthelmintic properties [12].
Some flavonoids like myricetin and kaempferol3-glucoside have an anti-HIV-I potency at a non-toxic concentration [13]. Some of the minor flavonoids have very interesting activities. They have anti-microbial, anti-fungal and cytotoxic properties. 10 Anthocyanin, peonin, and isorhamnetin of the algae Chlamydomonas are highly potent sex-determining hormone. 8 The health effects of flavonoids have long been recognized for anti-oxidant, anti-inflammatory, anti-allergic, hepatoprotective, antithrombotic, antiviral, and anti-carcinogenic properties [14]. Isoflavones, the bioactive ingredient in leguminous vegetables, not only cause a small reduction in blood cholesterol but also reduce blood pressure, arterial dimensions, and oxidative stress [15].
RESULTS AND DISCUSSION
Identification of the isolated compound
The IR spectrum of a compound (Figure 1) (KBr disc) spectrum was showed ν 3520(OH), 1608 (C=O), 1569, 1528, and 1476 (C=C, Ar), 1116 (C-O), 854, 808, 770 cm-1 (C-H, Ar, bending).
The isolated compound gave UV absorption characteristic flavonol revealed λmax (MeOH) 248, 363 nm (Figure 2A). Addition NaOMe to a methanolic solution gave a 41 nm (Figure 2B) bathochromic shift in a band I without a decrease in intensity and this is diagnostic of a free 4`-OH. Sodium acetate spectrum (Figure 2C) gave a 17 nm band II bathochromic shift which is indicating a 7-OH function. The boric acid spectrum (Figure 2D) revealed an 18 nm bathochromic shift in band 1, indicating the presence of a B ring catechol moiety. When AlCl3 was added to a methanolic solution, a band I shifted bathochromically by 67 nm (Figure 2E). This indicates a 3- or 5-OH or an ortho-dihydroxyl system. The spectrum was acid-stable (Figure 2F) this indicating of a 3-OH function.
1H-NMR showed doublet at δ 7.8 ppm (1H) characteristic of C5- proton (Figure 3). The doublet at δ. 6.8 ppm (2H) is characteristic of C6- and C8- protons. The doublet at δ. 7.6 ppm (2H) is account for C2`- and C6`-protons while the doublet at δ.7.4 ppm (1H) was assigned for C5`- proton.
Mass spectrum of the isolated compound shown at base beak m/z 286 (Figure 4). According to the above cumulative data, the following structure suggested a compound is: 7, 3`, 4`-trihydroxyflavonol (Figure 5).
Antimicrobial activity
The antimicrobial activity of the tested compound was examined against selected gram positive-bacteria and gram-negative bacteria in comparison to reference antibiotics (Figure 6). Results revealed that the tested compound had different antimicrobial responses (Table 1). The gram-positive bacteria which were inhibited were Bacillus cereus, Corynebacterium sp., Enterococcus faecalis, Staphylococcus aureus, and Streptococcus agalactiae. The gram-negative bacteria were Acinetobacter baumannii, Acinetobacter sp., Escherichia coli, Pseudomonas aeruginosa. The inhibited yeasts were Candida albicans and Cryptococcus neoformans.
| Microorganism | Source / Code | Inhibition zone diameter (mm / mg sample) |
|---|---|---|
| Gram-positive bacteria | ||
| 1. Bacillus cereus | Laboratory isolates | 15 |
| 2. Corynebacteriumdiphtheriae | ATCC 13812 | 10 |
| 3. Enterococcus faecalis | ATCC 19433T | 12 |
| 4. Staphylococcus aureus | ATCC 25923 | 26 |
| 5. Staphylococcus aureus | Clinical isolate | 18 |
| 6. Streptococcus agalactiae | ATCC 13813T | 15 |
| Gram-negative bacteria | ||
| 7. Acinetobacter baumannii | ATCC 19606T | 19 |
| 8. Acinetobacter sp. | Clinical sample | 20 |
| 9. Escherichia coli | ATCC 25922 | 22 |
| 10. E. coli | Clinical sample 4662 | 20 |
| 11. Pseudomonas aeruginosa | ATCC 27853 | 22 |
| Yeasts | ||
| 12. Candida albicans | ATCC 10231 | 15 |
| 13. Cryptococcus neoformans | Clinical isolate; VY 4662 | 16 |
n conclusion, the compound, 7, 3`, 4`-trihydroxyflavonol, was extracted and isolated from A. nilotica var. adstringes (collected from Kordofan area, western Sudan). The isolated compound was extracted with methanol and purified using the TLC technique, the structure of the isolated compound was studied and identified using Uv & vis, IR, H1-NMR, and Mass spectra. The biological activity was studied and showed good results.
Experimental
Plant materials The heartwood of A. nilotica var. adstringens was collected from Elobied, North Kordofan, Sudan. The plant was authenticated by the Department of Botany, University of Khartoum, Sudan.
Extraction of flavonoids
Powdered air-dried heartwood (1 kg) of A. nilotica var. adstringens was extracted with 80% methanol (5 L) at ambient temperature for 72 hours. The solvent was removed in vacuum to give a crude product.
Isolation method
The methanol extracts of A.nilotica var. adstringens were separately slurred with water, mixed with a small amount of polyamide and applied on top of the polyamide (800 g) column (100×5cm). Stepwise gradient elution was carried out using a solvent system of decreasing polarity starting with 100% water and ending with 100% methanol. Fractions of 250 ml were collected and investigated by PC (what man No. 1) using three solvent systems: BAW, 15% AcOH and distilled water. Chromatograms were visualized under UV light before and after exposure to ammonia vapor. Similar fractions were companies and concentrated to dryness under reduced pressure to obtain main fractions. The detected compound was isolated by subsequent PPC from column fraction using different solvent systems (BAW, 15% AcOH). The isolated compound was further purified by re-chromatography on Sephadex LH-20 column using MeOH/H2O, 4: 1.
Preparation of bacterial suspensions
One ml aliquots of 24-hours growth culture of the test organisms were aseptically distributed on to agar slopes and incubated at 37°C, for 24 hours. The bacterial growth was harvested and washed off with sterile normal saline, and finally suspended in 100ml of normal saline to produce a suspension containing about 108–104 colony forming units per ml. The suspension was stored in the refrigerator at 4ºC until used. The average number of the viable organism per ml of the saline suspension was determined through the surface viable counting technique. Serial dilution of the stock suspension was made in sterile saline in tubes and on drop volumes (0 ml-20ml) of the appropriate dilution were transferred by adjustable volume micropipette onto the surface of dried nutrient agar plates. The plates were allowed to stand for two hours at room temperature for dry and then incubated at 37ºC for 24 hours.
Antimicrobial assay
The cub-plate agar diffusion method adopted with some minor modifications, to assess the antimicrobial activity of Munich bases and their reaction products with o-phenylenediamine, 2 ml of the standardized bacterial stock suspension was mixed with 200 ml of sterile molten nutrient agar which was maintained at 45ºC in the water bath. (20 ml) Aliquots of the incubated nutrient agar were distributions into sterile Petri dishes; the agar was left to settle in each of these plates which were divided into two halves. Two cubs in each half (10 mm in diameter) were cut using sterile cork borer (No. 4). Each of the wholes was designed for one of our compounds. Separate Petri dishes were designed for standard antibacterial chemotherapeutic (ampicillin and gentamycin).
The agar discs were removed, a hamates cup were filled with 0.1 ml samples of each compounds using adjustable volume microtiter pipette and allowed to diffuse at room temperature for two hours. The plates were then incubated in the upright position at 37ºC for hours.
The above procedure was repeated for different concentrations of the isolated compounds and the standard antimicrobial chemotherapeutic. After incubation, the diameters of resultant growth inhabitation zones were measured.
Acknowledgment
The authors would like to express their gratitude to the Deanship of Scientific Research at King Khalid University for funding this work under grant number G.R.P-192-39.
References
[1] S. Anita, VK Shakya, A Neetu et al., Preliminary Physical-Phytochemical Study of the bark of A. nilotica. RJPBC. 2012. 3: p. 84-5.
[2] E. Grotewold. The Science of Flavonoids. New York: Kluwer Academic Pub., 2006.
[3] RD Barnes and CF Fagg. The potential of the African acacias in agricultural systems in the dry land tropics. Invited paper, IUFRO XX World Congress. 6-12 August, 1995, Tampere, Finland. p. 12.
[4] RK Mishra, M Ramakrishna, V Mishra et al., Pharmaco-Phylogenetic Investigation of Methyl Gallate Isolated from Acacia nilotica (L.) Delile and Its Cytotoxic Effect on NIH3T3 Mouse Fibroblast. Current pharmaceutical biotechnology. 2016. 17: 540-8.
[5] Barnes R and Harris SA. African Acacias - monographs and Manuals Final Technical Report, p. 21- 26. Oxford: Oxford Forestry Institute, University of Oxford, 2002.
[6] Rehman SU, Choe K and Yoo HH. Review on a Traditional Herbal Medicine, Eurycoma longifolia Jack (Tongkat Ali): Its Traditional Uses, Chemistry, Evidence-Based Pharmacology and Toxicology. Molecules. 2016; 21: 331.
[7] Amos S, Akah PA, Odukwe CJ, Gamaniel KS and Wambede C. The pharmacological effects of an aqueous extract from Acacia nilotica seeds. Phytotherapy research : PTR. 1999; 13: 683-5.
[8] Sadiq MB, Tarning J, Aye Cho TZ and Anal AK. Antibacterial Activities and Possible Modes of Action of Acacia nilotica (L.) Del. against Multidrug-Resistant Escherichia coli and Salmonella. Molecules. 2017; 22.
[9] Lin D, Xiao M, Zhao J, et al. An Overview of Plant Phenolic Compounds and Their Importance in Human Nutrition and Management of Type 2 Diabetes. Molecules. 2016; 21.
[10] Duke JA, Duke P-AK and DuCellier JL. Duke's handbook of medicinal plants of the Bible. Boca Raton, FL: CRC Press, 2008, p.528 p.11. Atif A, Naveed A, Barkat AK, et al. Acacia nilotica: A plant of multipurpose medicinal uses. Journal of Medicinal Plants Research. 2012; 6: 1492-6.
[12] Akintunde TA, Babayi HM and Alfa S. Effect of Aqueous Extract of Acacia Nilotica on Microbial and Castor Oil Induced Diarrhoea. Nigerian Journal Biotechology. 2015; 29: 34-7.
[13] Abreu AC, Serra SC, Borges A, et al. Combinatorial Activity of Flavonoids with Antibiotics Against Drug-Resistant Staphylococcus aureus. Microbial drug resistance. 2015; 21: 600-9.
[14] Middleton E, Jr., Kandaswami C and Theoharides TC. The effects of plant flavonoids on mammalian cells: implications for inflammation, heart disease, and cancer. Pharmacological reviews. 2000; 52: 673-751.
[15] Taku K, Umegaki K, Sato Y, Taki Y, Endoh K and Watanabe S. Soy isoflavones lower serum total and LDL cholesterol in humans: a meta-analysis of 11 randomized controlled trials. The American journal of clinical nutrition. 2007; 85: 1148-56.